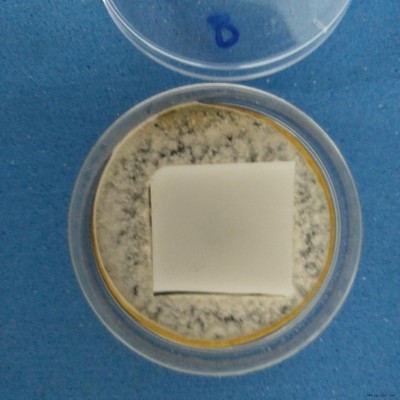

| 品牌 : | 國產(chǎn) | 型號(hào) : | KP-J142 | 
| 外觀 : | 防霉液 | 產(chǎn)品規(guī)格 : | 25kg | 
| 主要用途 : | 橡膠用 | 有效物質(zhì)含量 : | 99 | 
| 適用范圍 : | PU、PVC、EVA、EPP、 | 特色服務(wù) : | 免費(fèi)拿樣品測(cè)試 | 
發(fā)泡抗菌劑 KP-J142鞋材發(fā)泡防霉劑EVA海綿發(fā)泡防霉抗菌劑
發(fā)泡抗菌劑產(chǎn)品概述
我司自主研發(fā)的發(fā)泡抗菌劑 KP-J142屬于PU、PVC、EVA、EPP、PE、PU、TPE等軟性塑膠的專用抗菌劑,保護(hù)發(fā)泡材料免細(xì)菌的侵蝕,并賦予其抗菌除臭效果。外觀為無色透明液體,其耐溫性可達(dá)230以上。

發(fā)泡抗菌劑產(chǎn)品特征
1、抗菌性能優(yōu)異、殺菌廣譜、尤其對(duì)藻類、細(xì)菌、酵母、酶菌等有效;
2、與大多數(shù)工業(yè)產(chǎn)品相容性良好,分散均勻,易于運(yùn)輸,使用方便;
3、對(duì)人體刺激性小,產(chǎn)品安全環(huán)保,符合歐盟相關(guān)法規(guī);
4、可耐溫230,化學(xué)性質(zhì)穩(wěn)定,耐雨淋、耐紫外,優(yōu)良的耐候性;
5、與大多數(shù)多聚物配方體系相容,不會(huì)引起變色。
項(xiàng)目  | 指標(biāo)  | 
外觀  | 無色透明液體  | 
密度  | 0.97g/ml  | 
耐熱性  | 大于230  | 
有效含量  | 25  | 
發(fā)泡抗菌劑應(yīng)用范圍
PU、PVC、EVA、EPP、PE、PU、TPE等軟性塑膠。
發(fā)泡抗菌劑使用說明
1、如軟質(zhì)塑膠、有機(jī)硅化合物及木塑復(fù)合材料中,添加0.81.5的量,即可制成防酶抗菌制品。
2、添加0.50.8的量,即可制成抗菌制品。
備注:本品對(duì)易過敏者會(huì)造成眼睛和皮膚有刺激,使用操作時(shí)必須戴手套、眼罩和口罩。避免接觸皮膚、眼睛和粘膜。一旦與皮膚和眼睛接觸立即用大量清水及肥皂清洗并及時(shí)就醫(yī)。